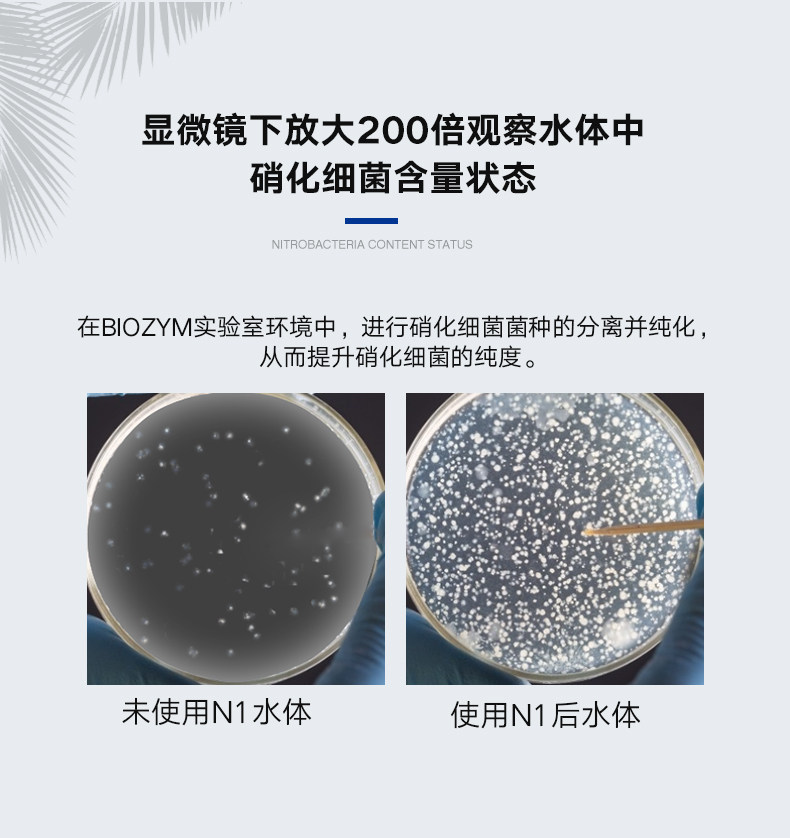
百因美硝化细菌鱼缸用消化细菌液体净水剂活菌水族净水养鱼用品

硝化细菌图片

本帖主要讨论是否需要额外添加硝化细菌,开缸添加硝化细菌可以加速
图片尺寸1080x668
市售硝化细菌制剂可分为活菌及休眠菌两种,前者是利用细菌的活体制成
图片尺寸800x320
误区新手使用硝化细菌最容易犯的3个错误
图片尺寸928x686
硝化细菌应该属于什么型的微生物呢
图片尺寸640x331
硝化细菌应该属于什么型的微生物呢
图片尺寸640x320
为什么我的硝化细菌这样子
图片尺寸828x1104
十川硝化细菌评测
图片尺寸600x800
硝化细菌
图片尺寸540x960
硝化细菌菌丝
图片尺寸1280x960
硝化细菌微生物水产养殖水质调控底质改良 降解氨氮 反硝化细菌
图片尺寸750x750
硝化细菌是原核生物吗】属于原核生物的是发菜细菌吗_尚书坊
图片尺寸650x487
请教这些是什么是硝化细菌吗
图片尺寸1984x1488
硝化细菌正常吗
图片尺寸2016x1512
水质的核心硝化细菌
图片尺寸828x611
可生化污水中氨氮的生物降解技术路线和原理(之二)强微环保硝化细菌
图片尺寸700x396
硝化细菌需要光照吗硝化细菌的使用方法
图片尺寸600x400
百因美硝化细菌鱼缸用消化细菌液体净水剂活菌水族净水养鱼用品
图片尺寸790x838
宣歌鱼缸水族箱观赏鱼硝化细菌硝化菌干粉 硝化细菌胶囊 净化水质
图片尺寸790x1365
硝化细菌降解氨氮亚硝酸盐净化水体
图片尺寸1557x1557
硝化细菌
图片尺寸1728x2304